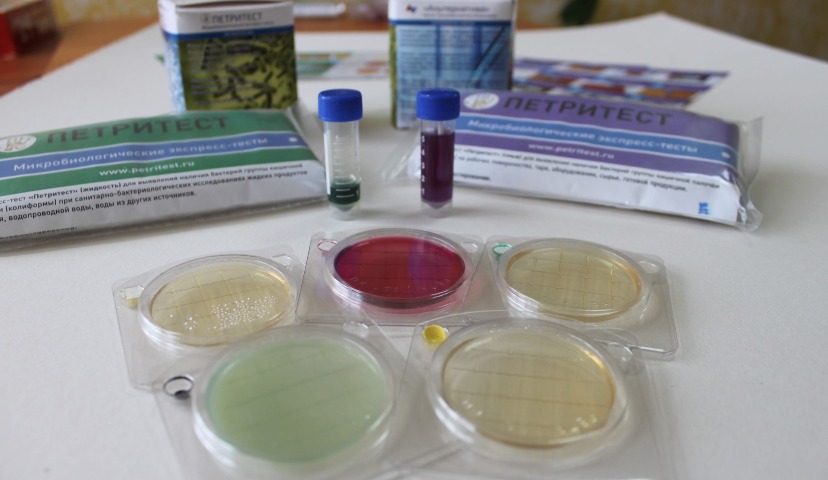
Контроль пищевой безопасности на мясном производстве

Контроль пищевой безопасности на мясном производстве
Контроль гигиены и микробиологический анализ на мясном производстве также важен, как на любом другом пищевом предприятии.
Потребитель, приобретая продукты, должен быть уверен в их качестве. Этикетка с информацией о сроке годности и составе продукта помогают нам сделать выбор в магазине. При этом необходимо отчетливо понимать, что этикетка – лишь вершина айсберга, на самом деле на качество продукции влияет огромное количество показателей.
Среди них – состояние сырья, хранение и транспортировка товара, температурные показатели при раскладке в магазине, и, конечно же, контроль технологического процесса на каждом его этапе.
Для этого на любом предприятии пищепрома осуществляется микробиологический анализ и контроль санитарно-гигиенических показателей. Каждое предприятие решает, каким образом осуществляется этот контроль в зависимости от своих мощностей и потребностей. Так, часть заводов отдают предпочтение собственной лаборатории, кто-то принимает решение обратиться в стороннюю организацию.
Создание внутренней лаборатории предполагает свои издержки – отдельное помещение, достаточно большой бюджет на оборудование, расходные материалы и фонд заработной платы. Риски внешней лаборатории – это длительность проведения анализов на патогенные микроорганизмы, зачастую неудобная логистика, возможная путаница при проведении анализов, хранении и доставке образцов.
Поэтому все больше и больше пищевых предприятий переходят на современные, высокотехнологичные методы проведения микробиологических исследований непосредственно на производстве. Среди таких разработок можно назвать микробиологические экспресс-тесты «Петритест» от научно-производственного объединения «Альтернатива».
С помощью данных микробитестов можно оперативно проводить мониторинг качества пищевых продуктов, начиная от сырья, заканчивая готовыми изделиями. Подчеркну, что ключевое слово здесь «оперативно». Один из самых ценных ресурсов на предприятии это время, и технологиям, позволяющим ускорить производственные процессы, безусловно, оказывают предпочтение. А «Петритесты» экономят и время и деньги. Время – потому что для проведения анализов не нужно отдельно варить среды (они уже готовые в тесте), а смыв на БГКП уже через четыре часа покажет, есть ли в образцах кишечная палочка. Средства – потому что для использования «Петритестов» нет необходимости в закупке дорогостоящего оборудования, расходников, найма лаборантов или траты на исследования в сторонней организации.
Разнообразие «Петритестов» позволяет провести исследование на разных этапах производства. Так, смыв на моющие средства поможет практически моментально определить остатки моющих средств на оборудовании и запустить следующий цикл производства. Экспресс-тесты на бактерии группы кишечной палочки представлены в нескольких видах, по необходимости проводится качественный или количественный анализ.
Широк и сам спектр микроорганизмов, которые можно проверить «Петритестами»: общее микробное число (КМАФАнМ), кишечка, дрожжи и плесневые грибы, сальмонелла, стафилококк, молочнокислые бактерии и листерии.
Внедрение таких разработок на предприятие ускоряет процесс принятия производственных решений. О чем идет речь? Например, классические исследования образцов на патогены в сторонней организации занимают от 7 до 10 дней (!). Благодаря «Петритестам» этот период сокращается до одних суток и, следовательно, сокращается время отгрузки с производства в магазины, оптимизируется процесс логистики. Ведь чем быстрее стали известны результаты анализов, тем быстрее можно отгрузить партию.
Отмечу, что НПО «Альтернатива» сотрудничает с предприятиями на протяжении всего цикла производства. От микробиологического анализа оборудования и сырья «Петритестами» мы переходим непосредственно к производству мясной продукции с использованием пищевых добавок линейки «Униконс». Завершается цикл выходным контролем готовой продукции опять-таки с помощью «Петритестов».
Такое взаимодействие помогает более ответственно подходить к микробиологическому мониторингу, а внедрение современных, технологических методов повышает качество выпускаемой продукции, уверен руководитель группы научных разработок НПО «Альтернатива».
Контакты:
НПО «Альтернатива»
alternativa-sar@yandex.ru
www.alternativa-sar.ru
тел.: 8-962-622-34-29
Автор материала – Ирина Правская, руководитель направления разработки «Константа ИТ» Материал подготовлен совместно с партнером комьюнити по...
В пятницу, 20 марта 2026 года прошел форум АПК 360, где принимало участие много именитых и известных отраслевых деятелей и...
Материал подготовлен совместно с комьюнити Digital4food и Ириной Правской, руководителем направления разработки «Константа ИТ» И вот момент...
Парейдолия - это распространенная зрительная иллюзия, при которой мозг, стремясь распознать знакомые образы, «дорисовывает» базовые...
Новинки Останкино (ТМ "Папа Может", "Останкино", "Коровино") на выставке ПРОДЭКСПО 2026 ...
Коллеги цифровизаторы-интеграторы, айтишники и все умеющие отличать штрих-коды от...
Уважаемые коллеги здравствуйте. скажите пожалуйста кто уже подал заявку на участие в пилотном...
ну или креазот и деготь вам на стол для вашей печени. Фото снято в ноябре 2025...
Здравствуйте. Остаётся щетина после обесволашивания. Пробовали увеличение циклов, замену бил,...
Здравствуйте, уважаемые! Посоветуйте, пожалуйста. Предлагают по 80000 рублей две термокамеры...
Добрый вечер всем. Когда то писал письмо в ВНИИМП по данным книгам, которые они издавали, на...











Термостат нужно покупать? Какие требования к нему?
Что ты имеешь ввиду? Нужен ли посев? Ты про фразу "а смыв на БГКП уже через четыре часа покажет, есть ли в образцах кишечная палочка."?
@injener так как для инкубации необходима температура 35-37°С , то термостат нужен.
Единственным тестом для которого не нужен термостат - это «Петритест» для выращивания и подсчета общего числа дрожжевых и плесневых грибов.